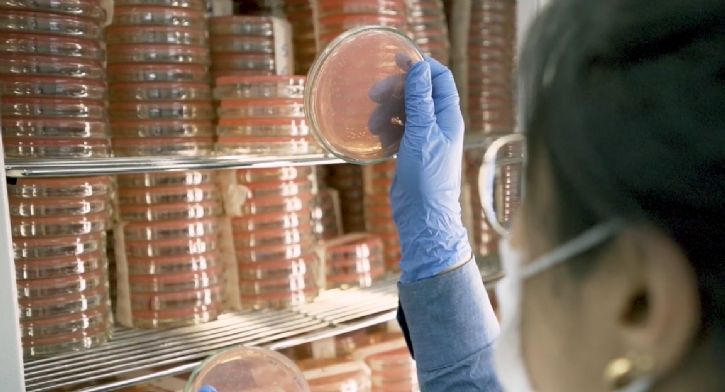

- mell280
30/11/2025 08h11
Biotrop é uma das 10 empresas mais inovadoras do país
Empresa integra o ranking da Forbes Brasil que lista as organizações que impulsionam o futuro, em diversos setores.
A Biotrop é destaque na lista das Empresas mais Inovadoras do Brasil,
que reconhece companhias que aceleram o desenvolvimento e a incorporação de novas tecnologias para impulsionar o futuro. O ranking, iniciativa da revista Forbes Brasil, reúne um seleto grupo de dez empresas de diferentes setores da economia que se destacam pela capacidade de inovar de forma consistente, impactando diretamente suas cadeias de valor e o desenvolvimento do país.
Com uma equipe de cerca de 70 profissionais na área de pesquisa e inovação, centros no Brasil e unidades nos Estados Unidos e Europa, além de dezenas de pedidos de patentes registrados, a Biotrop se consolida como referência global em tecnologias biológicas e naturais voltadas para a agricultura.
Destaque para a Biooracle, centro de pesquisas instalado em Santo Antônio de Posse (SP), onde as tecnologias são testadas, analisadas e aprimoradas para diferentes cenários produtivos. Os resultados são cruzados com protocolos de pesquisa de instituições independentes, permitindo à Biotrop antecipar problemas, compreender padrões de comportamento do sistema e acelerar o desenvolvimento de novas soluções para os grandes desafios do campo.
A empresa possui três Centros Avançados de Multiplicação de Microrganismos (CAMM) – dois em Curitiba e um em Jaguariúna, e conta com mais de trezentos profissionais a campo para atendimento aos clientes.
Esse ecossistema de inovação faz da Biotrop a empresa de soluções para agricultura que mais registra produtos inéditos no mercado de biológicos no Brasil, reforçando seu propósito de transformar o agro inovando com biológicos para produção de alimentos saudáveis, energia limpa e fibras de qualidade.
"Estar entre as 10 empresas mais inovadoras do Brasil na lista da Forbes Brasil é uma conquista que nos enche de orgulho e reafirma a força de uma cultura que escolhe inovar todos os dias, abrindo novos caminhos para o futuro do agro. Nossos biológicos são protagonistas de uma revolução poderosa. O movimento é acelerar, com consistência, parcerias de longo prazo, confiança e foco no cliente. Estamos apenas começando!”, destaca Jonas Hipólito, Presidente da Biotrop.
Sobre a Biotrop
A BIOTROP é uma das líderes em soluções biológicas e naturais para o agronegócio. Tem como foco a pesquisa e o desenvolvimento de soluções inovadoras, visando contribuir para uma agricultura sustentável, saudável e regenerativa. Com escritório em Vinhedo (SP), Centros Avançados de Multiplicação de Microrganismos (CAMMs) em Curitiba (PR) e Jaguariúna (SP) e distribuidores parceiros em vários países, a empresa oferece as melhores soluções biológicas e naturais ao mercado. Desde 2023, a BIOTROP integra o Grupo BioFirst, que é líder global em tecnologias biológicas e naturais, com presença em mais de 70 países. Mais informações: https://biotrop.com.br/